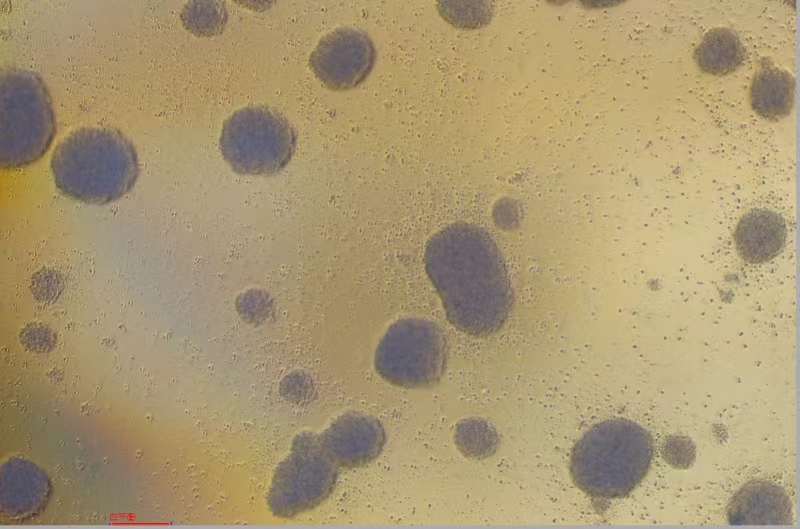

|
种属 |
人 |
|
别称 |
C8166-CD4 |
|
组织来源 |
血液 |
|
疾病 |
转化细胞系 |
|
传代比例/细胞消化 |
1:2传代,维持细胞浓度在3*10^5-9*10^5cells/mL |
|
完全培养基配置 |
RPMI1640培养基;10%胎牛血清;2mM L-谷氨酰胺;1%双抗 |
|
简介 |
该细胞由原代脐带血细胞与患有T细胞白血病淋巴瘤患者的产HTLV-1病毒的细胞系融合获得。在HIV存在下细胞会融合成合胞体。 |
|
形态 |
淋巴母细胞样 |
|
生长特征 |
悬浮生长 |
|
倍增时间 |
每周 2 至 3 次 |
|
STR |
Amelogenin:X,Y;CSF1PO:10;D13S317:10,11;D16S539:12,13;D18S51:14,17;D21S11:27,30;D3S1358:15,16;D5S818:12;D7S820:9,10;D8S1179:11,14;FGA:21,22;PentaD:11,15;PentaE:7,11;TH01:6,9.3;TPOX:11;vWA:15,16 |
|
培养条件 |
气相:空气,95%;二氧化碳,5%。 温度:37摄氏度,培养箱湿度为70%-80%。 |
|
冻存条件 |
冻存液:90%FBS,DMSO 10%, 或使用非程序冻存液:官网货号JY-H040 |
|
保藏机构 |
ECACC; 88051601 |
|
备注 |
该细胞为悬浮细胞,请注意离心收集细胞悬液,请勿直接倒掉细胞培养液。 |
|
产品使用 |
仅限于科学研究,不可作为动物或人类疾病的治疗产品使用。 |